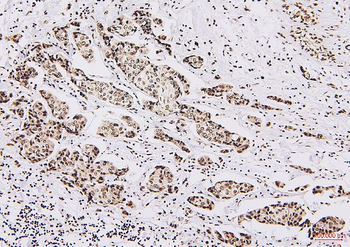
NRF1 Antibody (monoclonal, 2G4)

You have no items in your shopping cart.
- Cytokeratin 8 Mouse Monoclonal Antibody [orb500822]Featured

FC, IF, IHC-Fr, IHC-P
Human, Mouse, Rat
Mouse, Rat
Mouse
Monoclonal
Unconjugated
200 μg, 200 μl, 100 μl, 50 μl - Featured

IF, IHC-Fr, IHC-P, WB
Human, Mouse, Rat
Mouse, Rat
Mouse
Monoclonal
Unconjugated
200 μg, 100 μl, 200 μl, 50 μl - SNRNP200 Antibody [orb1474824]
ELISA, FC, ICC, IF, IHC, WB
Human, Mouse, Rat
Rabbit
Polyclonal
Unconjugated
100 μg - Elastin antibody [orb13391]Featured

ICC, IF, IHC-P, WB
Rabbit
Polyclonal
Unconjugated
100 μg, 200 μg, 15 μg - HADH Antibody [orb1940013]
ELISA, FC, ICC, IF, IHC, WB
Human, Mouse, Rat
Rabbit
Polyclonal
Unconjugated
100 μg IHC
Rabbit
Goat
Recombinant
HRP
10 x 5 ml, 3 x 5 ml, 5 ml- Alpha-Tubulin Antibody [orb344426]
ELISA, IF, IHC, Multiplex Assay, WB
Human
Mouse
Monoclonal
Unconjugated
25 μl - Bax Recombinant Rabbit Monoclonal Antibody [orb608054]Featured

FC, IF, IHC-Fr, IHC-P, WB
Human, Mouse, Rat
Mouse, Rat
Rabbit
Recombinant
Unconjugated
100 μl, 50 μl, 25 μl - Featured

IF, IHC-Fr, IHC-P, WB
Human, Mouse, Rat
Mouse, Rat
Mouse
Monoclonal
Unconjugated
100 μl, 50 μl - NRF1 Antibody (monoclonal, 2G4) [orb570325]
FC, ICC, IF, IHC, WB
Human
Mouse
Monoclonal
Unconjugated
100 μg